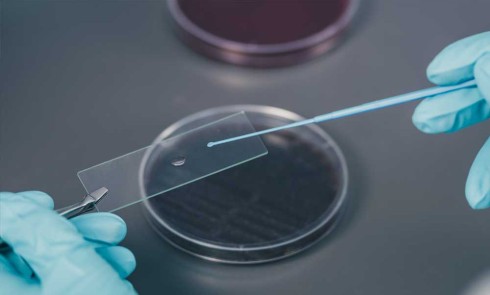

Antibiorésistance

Santé publique

Exercice professionnel
Convention dentaire : ce que contient le premier avenant signé le 4 juillet

Exercice professionnel
Antibiotiques en odontologie : la HAS va mettre à jour ses recommandations

Exercice professionnel
Endocardite infectieuse : l’ADF a mis à jour son « Guide des règles de prescription »

Santé publique

Santé publique
Santé publique









